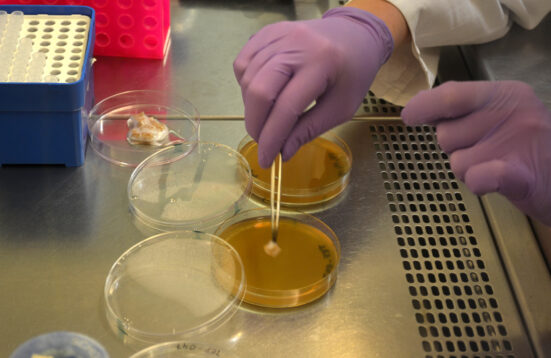

Mind the Fungi
Art & Design Residencies
Theresa Schubert | Fara Peluso
Das Artists-in-Residence-Programm bei Mind the Fungi mit Theresa Schubert und Fara Peluso bringt Kunst und Design mit konstruktiven Ideen in das multidisziplinäre Forschungsprojekt ein. Schubert hat sich mit den Auswirkungen von Schall auf das Pilzwachstum beschäftigt. Peluso hat nach neuen Biomaterialien unter Berücksichtigung der Symbiose von Algen und Pilzen geforscht. Die daraus resultierenden künstlerischen und designbasierten Arbeiten sind das Ergebnis einer engen Zusammenarbeit mit beiden Fachgebieten des Instituts für Biotechnologie der TU Berlin – der Angewandten Molekularen Mikrobiologie von Prof. Vera Meyer und der Bioverfahrenstechnik von Prof. Peter Neubauer.
Für die Künstlerin Theresa Schubert stellen Pilze die perfekte Grundlage für Netzwerkmetaphern dar, nicht nur ästhetisch, sondern auch als eine Philosophie der Beziehungen, des Prozesses und des Raums. Für ihr Box Experiment konstruierte sie Boxen, die Lautsprecher und ausgewähltes Pilzmyzel aus den Walk & Talks enthielten. Mehrere Wochen lang beschallte sie die Pilze mit bestimmten Tonfrequenzen. Schubert war begeistert zu sehen, dass sich dies auf das Wachstum und den Stoffwechsel des Myzels auswirkte. Daraus entwickelte sie die interaktive Videoinstallation Sound for Fungi. Homage to Indeterminacy, die Pilzhyphen simuliert und über einen Handtracking-Sensor Interaktion ermöglicht. Die Besucher:innen können hier als Tonfrequenz agieren, die das Wachstum der Hyphen moduliert und Bewegung durch das Netzwerk ermöglicht.
Die Künstlerin und Designerin Fara Peluso arbeitet in den Bereichen Material Driven Design und Biokunst und begreift den Menschen in einer engen Verbindung mit Natur, Organismen und biologischen Prozessen. Ihre Arbeit Niche ist eine hybride Installation einer lebenden Skulptur, welche die Koexistenz zwischen Pilzen und Algen als Mikroorganismen erforscht. Peluso lässt sich von der symbiotischen Beziehung zwischen diesen Organismen in Flechten inspirieren und verbindet Natur, Biotechnologie und Kunst. Die Skulptur Zweisamkeit kombiniert eine Topographie aus Eichenholz mit mehreren Schichten von Biomaterial, was sie als eine Form der Metamorphose begreift. Sie reflektiert die Entwicklung von Landschaft durch den Menschen, wobei der Schwerpunkt darauf liegt, wie wir unsere natürliche Umgebung definiert und geformt haben, aber wiederum von biologischen Kräften in der Umwelt geprägt werden.
Neben den Arbeiten von Schubert und Peluso stellt die Ausstellung auch neue Ergebnisse aus den Laboratorien des Instituts für Biotechnologie der TU Berlin vor, so hat zum Beispiel einen Prototyp eines Fahrradhelms aus Baumpilzmyzel von Bastian Schubert (Fachgebiet Angewandte und Molekulare Mikrobiologie) oder Beispiele von in Symbiose lebenden Organismen in Flechten (Fachgebiet Bioverfahrenstechnik).